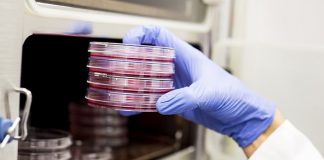
Nanomachines drill holes into cancer cells, Says New Study Nanomachines drill holes into cancer cells, Says New Study

DailyNews
477 POSTS
1 COMMENTS
Top News
Hey ISIS, You Suck: Local Muslims Post Anti-ISIS Billboard
A new billboard on Manchester Road in Missouri reads, "HEY ISIS, YOU SUCK!!! From: #ActualMuslims."
A group of Muslim-Americans have put up a blunt billboard...